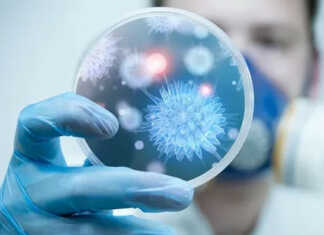
რუსეთში ახალი ჰასეკის ვირუსი აღმოაჩინეს

არასდროს მქონია კავშირი ე.წ. ქოლ ცენტრებთან, BBC-სთან ბევრი შეკითხვა მაქვს –...
საქართველოს თავდაცვის ექსმინისტრი, ტელეკომპანია „ფორმულას“ დამფუძნებელი დავით კეზერაშვილი ჟურნალისტური გამოძიების შესახებ, „ბიბისის“ გავრცელებულ ინფორმაციას განცხადებით გამოეხმაურა.
კეზერაშვილი ხაზგასმით აღნიშნავს, რომ არასდროს ჰქონია კავშირი BBC-ის პლატფორმაზე...
ჟერარ დეპარდიეს 13 ქალი სექსუალურ ძალადობასა და შევიწროებაში ადანაშაულებს
ფრანგ მსახიობ ჟერარ დეპარდიეს სექსუალურ ძალადობასა და შევიწროებაში ადანაშაულებენ. ფრანგული ვებ-გვერდის Mediapart-ის ინფორმაციით, მსახიობს 13 ქალი უყენებს ბრალდებებს.
როგორც ისინი ჰყვებიან, დეპარდიე მათ ხელებს უფათურებდა და უხამს...
“24 საათიც არ გასულა თარიღის გამოცხადებიდან და ჭკუა დაკარგეს, ტყუილად არ...
გურამ შარაძის შვილი რუსუდან შარაძე სოციალურ ქსელში წერს:
,,მეტი არაა ჩემი მტერი, რომ ერთუჯრედიან ტროლთა ჯოგი რამეს მიხვდეს, მაგრამ პატრონი ხომ ჰყავთ, პატრონი, ვინც დავალებებს...
ყველაზე მნიშვნელოვანი ცოლქმრულ ურთიერთობებში მეუღლეთა დაბადების წელია
ასტროლოგიის დანიშნულებაა, დაეხმაროს ადამიანებს ჰარმონიული ურთიერთობის მიღწევაში. ის გვასწავლის და მიგვითითებს, რომ არ შეიძლება, ადამიანს მოსთხოვო ის, რაც მას არ გააჩნია ან არ ესმის....
“თქვენ მიიღეთ ეს გიჟური სამყარო… მაკრონი, რომელიც ჩემი მეგობარია, ჩინეთში სი...
აშშ-ის ყოფილი პრეზიდენტის დონალდ ტრამპის განცხადებით, აშშ-მა დაკარგა გავლენა მსოფლიოში მას შემდეგ, რაც მან თანამდებობა დატოვა.
„თქვენ მიიღეთ ეს გიჟური სამყარო, რომელიც ფეთქდება და შეერთებულ...
„ელჩო დეგნან, არ ფიქრობთ რომ სულ ცოტა ბოდიში გაქვთ მოსახდელი ევროპელი...
კინორეჟისორი გოგა ხაინდრავა BBC-ის მიერ მომზადებულ სტატიას ეხმაურება, რომლის თანახმად ევროპელი პენსიონერების გაძარცვის თაღლითური სქემის ორგანიზატორი თავდაცვის ყოფილი მინისტრი და ტელეკომპანია „ფორმულას“ დამფუძნებელი დავით კეზერაშვილია.
გოგა...
მივმართავ კელი დეგნანს: დაასანქცირეთ ეს ადამიანი, მე ველოდები თქვენგან ობიექტურ რეაგირებას...
საპარლამენტო უმრავლესობის წევრმა ირაკლი ზარქუამ აშშ-ის ელჩს, კელი დეგნანს მიმართა და დავით კეზერაშვილისთვის სანქციების დაწესებისკენ მოუწოდა.
როგორც ზარქუამ აღნიშნა, „ბიბისის“ ჟურნალისტური გამოძიებით დადასტურდა, რომ დავით...
“ერთი გაბედე!” – ლალი მოროშკინა პრეზიდენტს მიმართავს
“ვაკის პარკში მემორიალი, რომელიც ეძღვნება მეორე მსოფლიო ომს, უნდა იყოს გადაკეთებული” - სალომე ზურაბიშვილი.
- ერთი გაბედე! ლალი მოროშკინა.
ლალი მოროშკინა, პოლიტოლოგი; სოციალური ქსელი
https://split.spnews.io/ka/archives/167697
პრეზიდენტი – „ვაკის პარკში“ მემორიალი, რომელიც მეორე მსოფლიო ომს ეძღვნება, უნდა...
„ვაკის პარკში“ მემორიალი, რომელიც ეძღვნება მეორე მსოფლიო ომს, უნდა იყოს გადაკეთებული. მეორე მსოფლიო ომთან ერთად, ყველა ჩვენი მებრძოლი და ადამიანი, რომელიც ამ ქვეყნის დამოუკიდებლობისთვის იბრძოდა,...
„პუტინს უკრაინა უყვარს და მას რუსეთის ნაწილად მიიჩნევს“ – ტრამპი
„პუტინს უკრაინა უყვარს და მას რუსეთის ნაწილად მიიჩნევს. ჩინეთის ლიდერი სი ძინპინი და ჩრდილოეთ კორეის დიქტატორი კიმ ჩენ ინი თავიანთ პოლიტიკურ თამაშში ძალიან ჭკვიანები...
“როგორ უხდება ახალი ვარცხნილობა” – ნახეთ ხვიჩა კვარაცხელიას ახალი იმიჯი
საქართველოს ნაკრებისა და “ნაპოლის” ვარსკვლავს, ხვიჩა კვარაცხელიას ახალი ვარცხნილობა აქვს.
ფოტოები სოციალურ მედიაში ვრცელდება.
წყარო: lelo.ge
BBC კეზერაშვილის თაღლითურ სქემას ამხელს
BBC-მ კეზერაშვილის ლონდონის 18 მილიონი ფუნტის ღირებულების სასახლეს მიაკვლია. ე.წ. ქოლცენტრების საქმეზე BBC-მ საგამოძიებო სიუჟეტი მოამზადა.
ჟურნალისტური გამოძიების ცნობით, ჯგუფ „მილტონის“ კომპანიებთან კავშირების მოკვლევის დროს 5...
უკრაინა თავად იღებს გადაწყვეტილებებს კონტრშეტევასთან დაკავშირებით – ბლინკენი
ტერიტორიების დეოკუპაციის მიზნით ეფექტური კონტრშეტევითი ოპერაციების ჩატარების შესახებ გადაწყვეტილებებს დამოუკიდებლად იღებს უკრაინის სამხედრო ხელმძღვანელობა, - ამის შესახებ აშშ-ის სახელმწიფო მდივანმა ენტონი ბლინკენმა განაცხადა.
მისი თქმით,...
უკრაინა კანადისგან ბირთვულ საწვავს შეისყიდის
უკრაინა ატომურ ელექტროსადგურებში გამოსაყენებლად ბირთვული საწვავის შესყიდვაზე კანადურ კომპანია „კამეკოს“ შეუთანხმდა.
კანადური კომპანია უკრაინას ბირთვული საჭიროებების დასაკმაყოფილებლად ურანს 2035 წლამდე მიაწვდის.
გადაწყვეტილება მიმდინარე წლის დასაწყისში მხარეებს...
ერთადერთი ევროპული ქვეყანა, რომელიც სუვერენიტეტს ინარჩუნებს, უნგრეთია, სწორედ ამიტომაა, რომ უნგრეთის...
ფილოსოფოსი ზაზა შათირიშვილი სოციალურ ქსელში მორიგ წერილს აქვეყნებს:
„მოვლენები, რომლებიც „კრედიტ სუისის“ წინააღმდეგ ბიძინა ივანიშვილის დავის გარშემო ვითარდება, კვლავაც გაოცებას იწვევს. სისტემატურად ვიღებთ ახალ მტკიცებულებებს...
რუსეთში ახალი ჰასეკის ვირუსი აღმოაჩინეს
რუსეთში ახალი ჰასეკის ვირუსი აღმოაჩინეს, რომელიც ტკიპების ნაკბენით გადადის, - ამის შესახებ ინფორმაციას რუსული მედია ავრცელებს.
„ჩვენ გავარკვიეთ, რომ ახალი ჰასეკის ვირუსი ადამიანზე გადადის ტკიპიდან და არსებობს...
რა გახდა ბესო მეგრელიშვილის გარდაცვალების მიზეზი
"ჩვენი თეატრისთვის 11 აპრილი მძიმე დღეა. დღეს ეს შემზარავი ამბავი მოხდა, მოულოდნელად ბესო მეგრელიშვილი დავკარგეთ და... ჩვენი მსახიობის, კოტე თოლორდავას გარდაცვალებიდან 8 წელი გავიდა..."...
ქართულ დიასპორაში ეროვნული იდენტობის, ენისა და საქართველოს შესახებ ცოდნის შენარჩუნება სახელმწიფოს...
დიასპორისა და კავკასიის საკითხთა კომიტეტის თავმჯდომარე ბექა ოდიშარია განათლებისა და მეცნიერების სამინისტროს საერთაშორისო ურთიერთობებისა და სტრატეგიული განვითარების დეპარტამენტის უფროს კახა ხანდოლიშვილს და ამავე დეპარტამენტის...
ვოლსკი რადიკალურ ოპოზიციაზე: ფაქტია, რომ ახალგაზრდებთან მათი ნებისმიერი შეკრება ორიენტირებულია აგრესიული...
პოლიტიკოსებს მეტი პასუხისმგებლობა მართებთ ქვეყნის წინაშე და ფაქტია, რომ მათი ნებისმიერი შეკრება, ურთიერთობები ახალგაზრდებთან სწორედაც რომ ორიენტირებულია აგრესიული აქციების გამართვის ორგანიზებისაკენ და აბსოლუტურად...
“მე კალაძის დამცავად არ გამოვდგები მაგრამ რატომ იკლავს თავს მაგათ გამო...
ჟურნალისტი მანანა მანჯგალაძე სოციალურ ქსელში სტატუსს აქვეყნებს და წერს:
„ე.ი მე ხომ მიყვარს დაკვირვება და დავაკვირდი, ქოცები რომლებიც ცდილობენ რომ ვითომ კრიტიკულები იყვნენ, ვითომ მაინც...